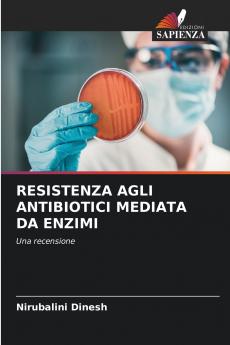
RESISTENZA AGLI ANTIBIOTICI MEDIATA DA ENZIMI
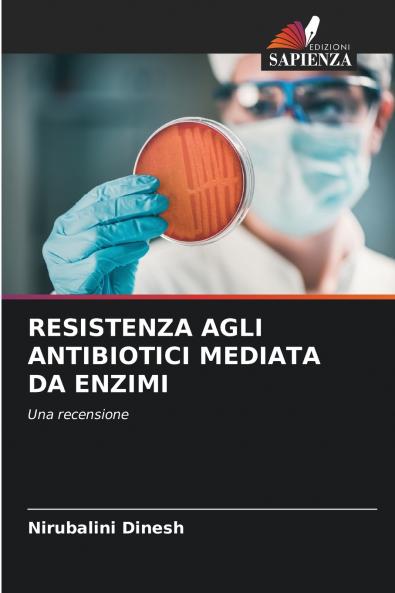
RESISTENZA AGLI ANTIBIOTICI MEDIATA DA ENZIMI

Italian
Paperback
₹4053
₹5894
31.24% OFF
(All inclusive*)
Delivery Options
Please enter pincode to check delivery time.
*COD & Shipping Charges may apply on certain items.
Review final details at checkout.
Looking to place a bulk order? SUBMIT DETAILS
About The Book
Description
Author
La resistenza agli antibiotici degli agenti causali delle malattie infettive è un problema sanitario mondiale in biologia e medicina. I meccanismi di resistenza agli antimicrobici usati per trattare le malattie infettive sono noti da prima che gli antibiotici fossero introdotti nell'uso clinico di routine. L'uso sconsiderato e spesso eccessivo di antimicrobici ha tuttavia aggravato il problema arricchendo le popolazioni batteriche resistenti a scapito di quelle sensibili. L'emergere della resistenza agli antibiotici comporta un aumento della mortalità della morbilità e dei costi di trattamento. Anche se sono emerse diverse indicazioni sull'uso improprio degli antibiotici da parte di operatori sanitari operatori non qualificati e consumatori di farmaci la consapevolezza e la sorveglianza sul controllo e la prevenzione dell'antibiotico-resistenza nel settore sanitario sono ancora inadeguate. Senza un'azione urgente ci stiamo dirigendo verso un'era post-antibiotica in cui infezioni comuni e lesioni minori possono tornare a uccidere. Questo libro si propone quindi di fare il punto sulla resistenza agli antibiotici mediata da enzimi e sui suoi meccanismi di sviluppo che è il meccanismo di resistenza più ampiamente caratterizzato. Inoltre raccomanda le misure di controllo.
Delivery Options
Please enter pincode to check delivery time.
*COD & Shipping Charges may apply on certain items.
Review final details at checkout.
Details
ISBN 13
9786205383407
Publication Date
-23-11-2022
Pages
-60
Weight
-95 grams
Dimensions
-152x229x3.65 mm